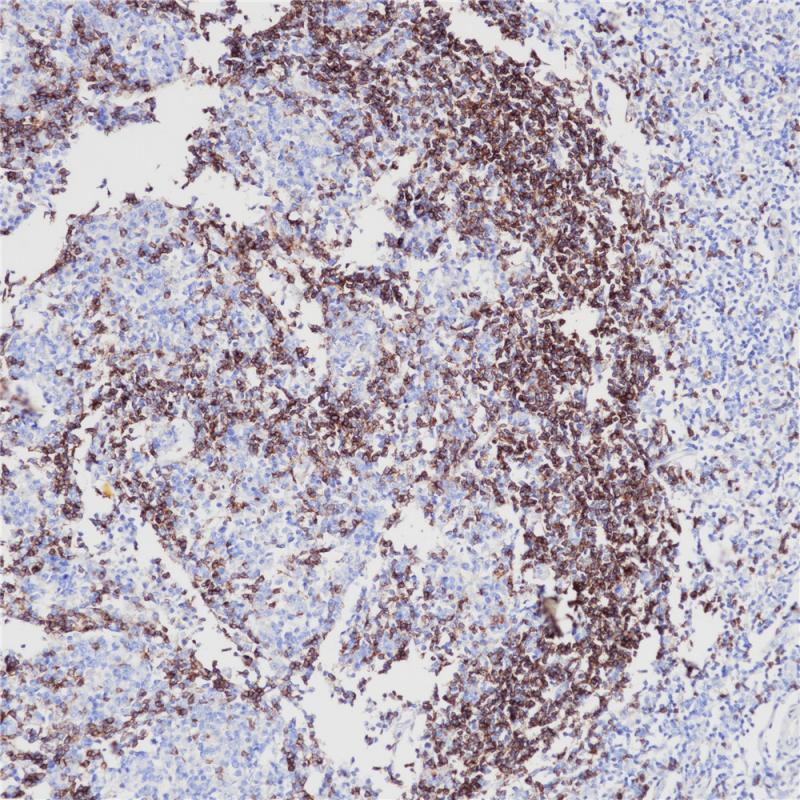
亚洲男人片片在线观看

产品中心

IgD 重组兔单克隆抗体
IgD抗体可以与免疫球蛋白IgD的δ链反应,用于淋巴瘤、浆细胞瘤和B细胞来源的霍奇金淋巴瘤的鉴别诊断
Specifications
- 目录号
- BX50130
- 克隆号
- BP6134
- 阳性对照
- 扁桃体
- 亚细胞定位
- 细胞质
- 组织类型
- FFPE
- 修复方式
- HIER
- 稀释比
- 1:100-1:200
- 规格
- 100μl/vial, 1ml/vial
- 用途
- RUO
Reference
1.Leong AS, et al., Geenwich Medical Media Ltd. 1999;217-219.
2.Arnold A, et al., New Eng J Med 1983; 309:1593-1599.


